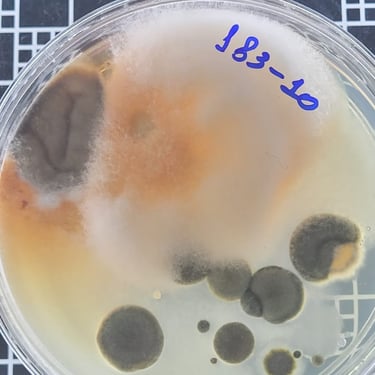
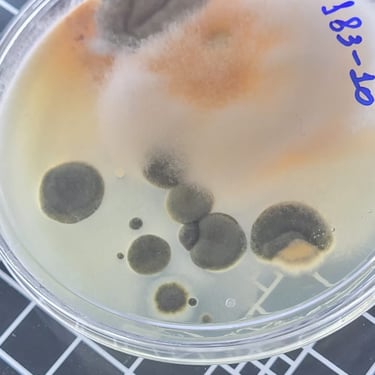
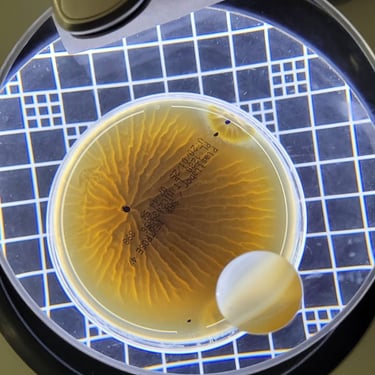
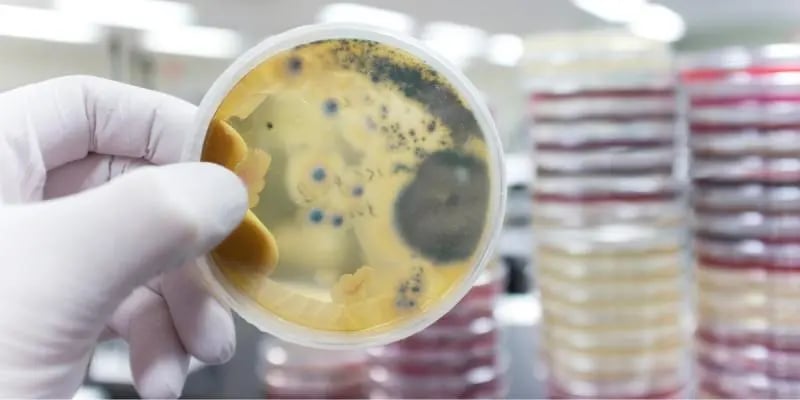
Profissional coletando amostras de água para análise de qualidade no Laboratório AMB
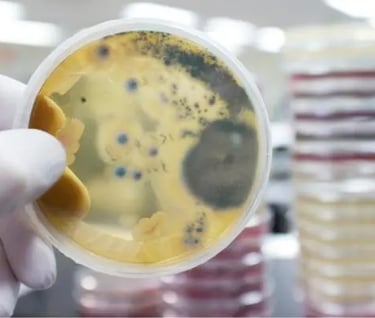
Profissional coletando amostras de água para análise de qualidade no Laboratório AMB

Grupo Acqualimp: Cuidando do seu ambiente com eficiência e precisão.
O Grupo Acqualimp nasceu da união de duas paixões: proteger ambientes e promover saúde. Combinando a experiência no controle de pragas urbanas com a precisão científica de análises químicas, reunimos soluções completas para garantir ambientes seguros, limpos e confiáveis.
Tudo começou com a Dedetizadora Acqualimp, reconhecida por sua eficiência no controle de pragas e atendimento personalizado, cuidando de residências e empresas com o compromisso de oferecer mais tranquilidade e qualidade de vida. Paralelamente, surgiu a necessidade de aprofundar o cuidado com o ambiente através de análises técnicas, dando origem ao nosso Laboratório de Química.
Hoje, atuamos em duas frentes complementares: o controle de pragas urbanas, limpeza de dutos, coifas, caixa d'água e análises especializadas em qualidade do ar interior em ambientes climatizados, Legionella e potabilidade da água. Essa combinação nos posiciona como referência em saúde ambiental, garantindo soluções integradas que impactam positivamente a vida das pessoas.
Mais do que serviços, o Grupo Acqualimp representa confiança, inovação e responsabilidade ambiental. Acreditamos que cada cliente é único, e nossa missão é oferecer não apenas resultados, mas também segurança, credibilidade e parceria em cada etapa.
Essa é a nossa história: construída com dedicação, aperfeiçoada pela ciência e fortalecida pela confiança de quem acredita no nosso trabalho. Seja em casa, no escritório ou na indústria, estamos aqui para cuidar do que realmente importa.

Missão
Promover ambientes saudáveis e seguros através de soluções especializadas em dedetização, limpeza de caixa d'água, limpezas de dutos, limpeza de coifas, análises químicas e biológicas, unindo eficiência, ciência e compromisso com a qualidade de vida.
Visão
Ser reconhecido como referência nacional em saúde ambiental, destacando-se pela excelência em controle de pragas, limpezas especializadas e análises laboratoriais, sempre em busca de inovação e impacto positivo no bem-estar das pessoas e empresas.


Valores
Compromisso com a Qualidade: Garantir serviços eficientes e resultados confiáveis, priorizando a satisfação do cliente.
Inovação e Ciência: Utilizar tecnologia e conhecimento para entregar soluções modernas e precisas.
Responsabilidade Ambiental: Atuar de forma sustentável, contribuindo para a preservação do meio ambiente.
Ética e Transparência: Conduzir nossas ações com integridade e clareza em todas as relações.
Cuidado e Parceria: Valorizar as necessidades de cada cliente, construindo relações de confiança e proximidade.
Valorização dos Colaboradores: Reconhecer e incentivar o papel essencial de nossa equipe, promovendo um ambiente de trabalho colaborativo, respeitoso e motivador.
Nossas Empresas
Conheça um pouco mais sobre nossas empresas:
Dedetizadora Acqualimp
A Acqualimp é uma empresa que está há 17 anos no mercado, atualmente prestando serviços de tratamento de água, limpeza de reservatórios e controle de pragas e vetores.




AMB Laboratório
Somos uma empresa comprometida com o bem-estar que atua oferecendo serviços técnicos e consultorias em qualidade visando o aumento da produtividade e melhoria da qualidade de vida dos colaboradores e da sociedade.
Links Rápidos
Contato
Orçamento
© 2024. All rights reserved. criado por carlamunizmktdigital
Conecte-se conosco
Política de privacidade
